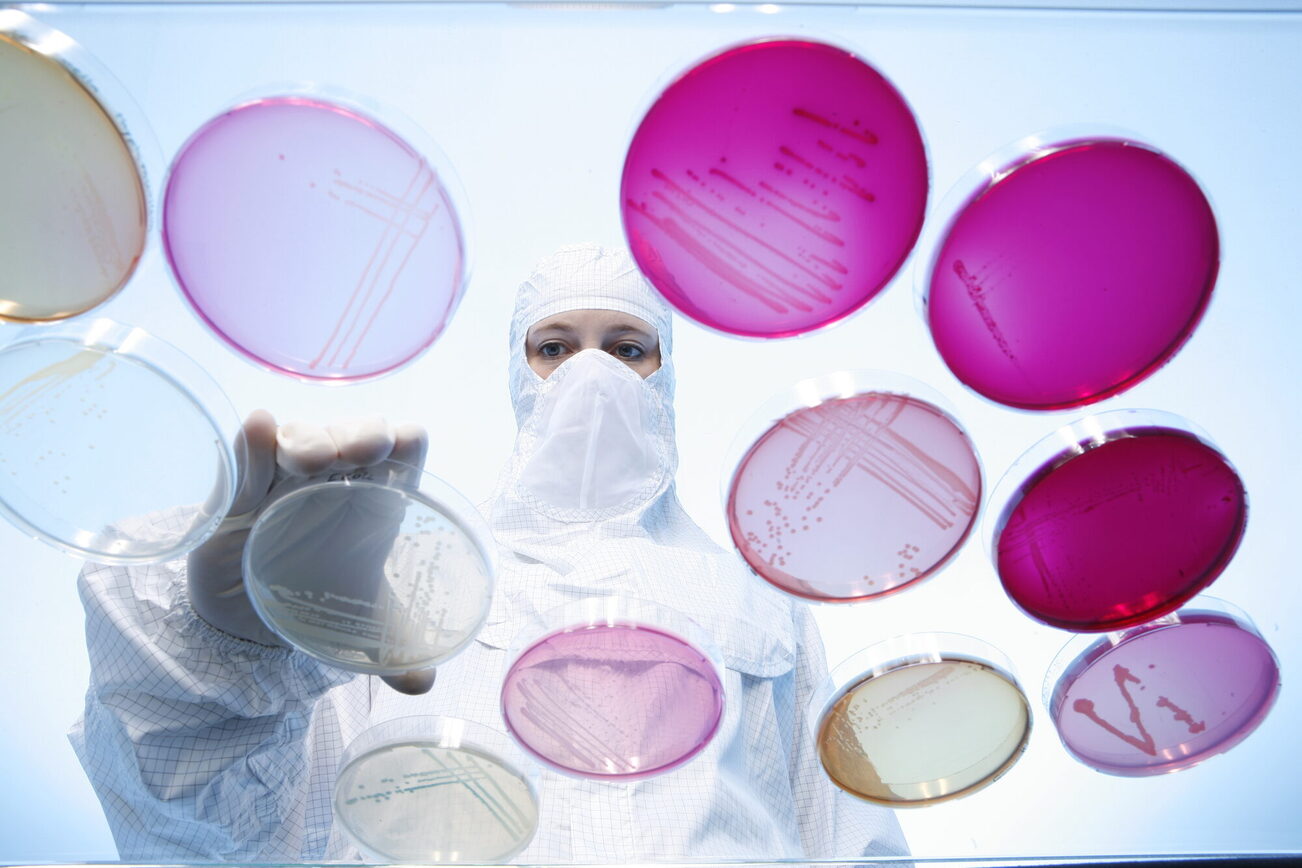
Samples in the laboratory

Mainz Science Alliance
Networking scientific potential
Johannes Gutenberg University, colleges, university hospitals, academies, institutes, museums, and numerous scientific research companies from Mainz and the surrounding area have joined forces to form the Mainz Science Alliance. The aim of the alliance is to raise awareness of Mainz's scientific potential, to establish effective networks between the alliance's partners, to enable them to benefit from each other, and to reinforce the self-image of researchers and teachers.
The Mainz Science Alliance (opens in a new tab) brings together nearly 4,000 scientists, who form the foundation of Mainz as a dynamic city of science through the continuous generation of knowledge, cooAlliance (opens in a new tab) brings together nearly 4,000 scientists, who form the foundation of Mainz as a dynamic city of science through the continuous generation of knowledge, cooperation and exchange, and the transfer of knowledge and technology to industry and society.
Contact us
Address
Wissenschaftsallianz Mainz
Mr.
MAINZER WISSENSCHAFTSALLIANZ e.V.
Carl-Zeiss-Straße 18-20
55129 Mainz